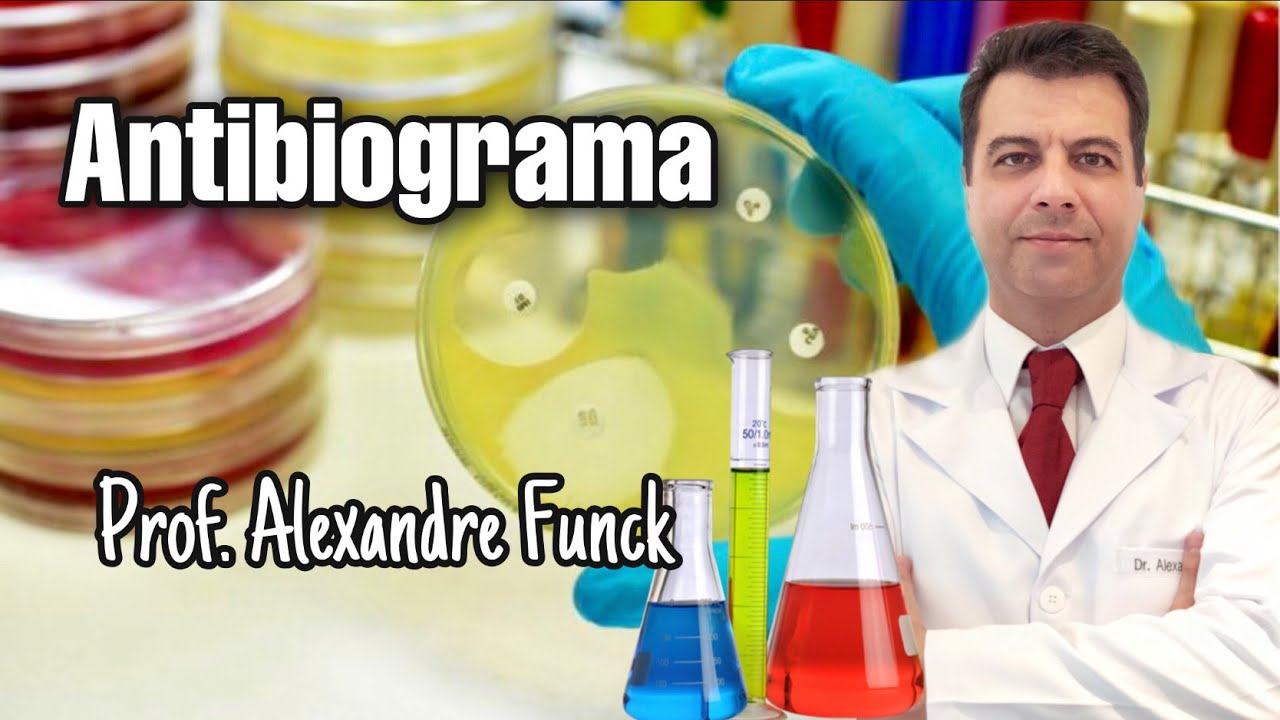
O ANTIBIOGRAMA - PROF. ALEXANDRE FUNCK
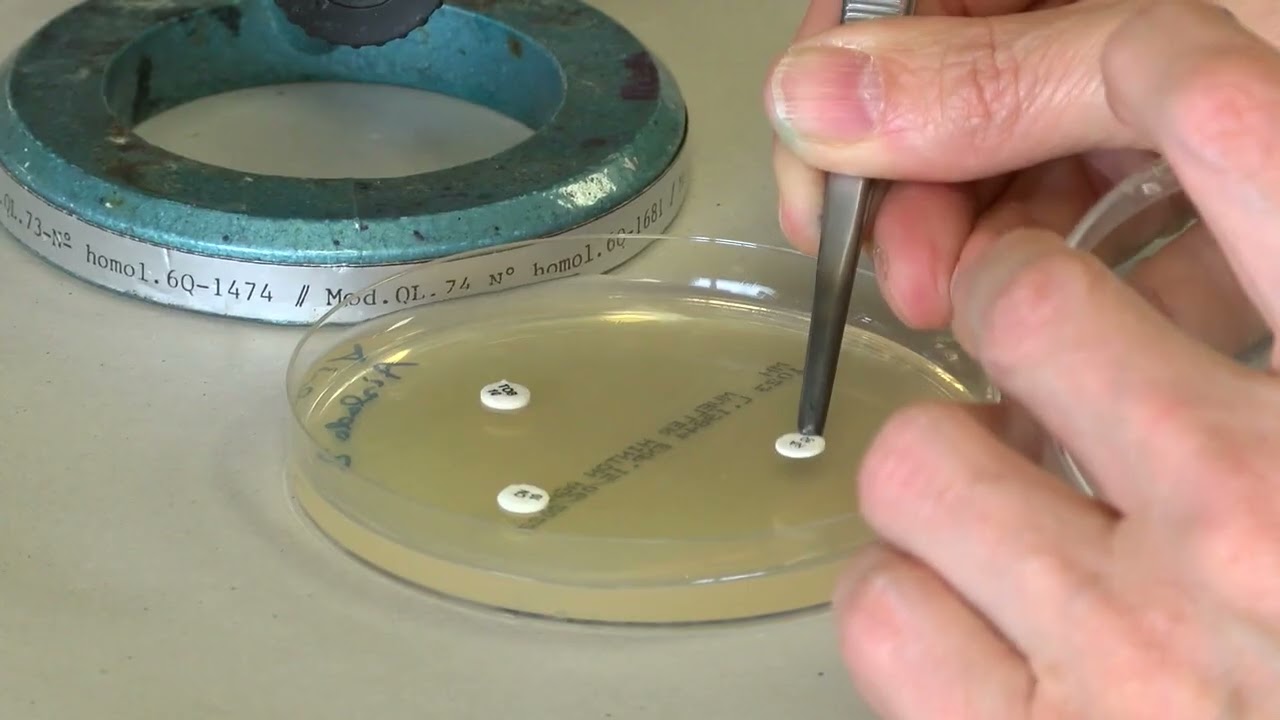
Antibiograma  Método Kirby Bauer

e aí e aí olá bem-vindos ao projeto é aula de dar cardiologia hoje vamos apresentar aula sobre os testes de suscetibilidade aos antimicrobianos tsa antibiograma tsa são metodologias que visam determinar in vitro a probabilidade do sucesso terapêutico de drogas utilizadas no tratamento de infecções causadas pelo microrganismo a ser testado por intermédio do antibiograma é possível mensurar a suscetibilidade das bactérias ação das drogas antimicrobianas o antibiograma é realizado pelo cultivo do microrganismo cuja a suscetibilidade sequer avaliar na presença de um ou vários antimicrobianos analisando-se a inibição de crescimento no meio onde estão presentes drogas ativas os
testes são divididos em qualitativos e quantitativos os testes quantitativos estão representados no vídeo sobre o método de cm na aula de hoje aprenderemos mais sobre o método qualitativo que a técnica mais usada na rotina da microbiologia a medida sua praticidade de execução baixo custo e confiabilidade de resultados apresentaremos agora o método que vi bauer também chamado de disco de fusão ou antibiograma que é o método qualitativo ou seja a partir desse teste de terminamos somente esse o microrganismo em questão apresenta sensibilidade resistência ou resistência intermediária ao antimicrobiano testado esta metodologia é padrão sendo amplamente utilizada
no mundo todo pois apresenta baixo custo praticidade de execução e confiabilidade nos resultados neste caso o meio de cultura padronizado é o arma energia então ou miller jim tão sangue neste último caso para bactérias fastidiosas estão empregados disco de papel de filtro impregnados com a droga de concentração padronizada cada disco possui impresso em suas faces abreviatura da droga e o valor numérico de sua concentração vamos à execução em beber o swab estéril em suspensão bacteriana na escala 15 de maxi lance obtida a partir da cultura pura em um meio líquido ou sólido comprimido contra as
paredes do túmulo para tirar o excesso da suspensão semear em seguida de forma suave em todas as direções da placa procurando abranger toda a superfície executando desta forma a técnica de semeadura por espalhamento aguardar a superfície do agreste secar por até quinze minutos com o auxílio de uma criança flambada e resfriada colocar os mono discos ou multidiscos sobre a superfície do meio inoculadas exercendo uma leve pressão com a ponta da pinça para uma boa adesão dos discos 1 e vale ressaltar que existe uma distância mínima entre os discos e também da borda da placa distância
a esta que deve ser preservada para que a interpretação do teste não seja prejudicada incubar a placa com os discos em estufa bacteriológica a 35 graus celsius por 16 a 18 horas para a leitura dos resultados devemos com auxílio de uma régua paquímetro ou dispositivo semelhante medir o diâmetro dos alunos em vitórias de cada disco o resultado é lindo e milímetros este método se baseia na difusão radial do antimicrobiano pelo agra após sua aplicação na superfície do meio de cultura é formado então um gradiente de concentração de crescente a partir do disco o resultado do
antibiograma é dado pela medição do diâmetro do aula de inibição do crescimento bacteriano ao redor do disco os diâmetros usados são conferidas conforme critérios definidos pelo cls o resultado é expresso através dos termos já viu intermediário e resistente após medir o tamanho de cada aluno e pesquisar o resultado obtido em tabelas apropriadas segundo a espécie da criana em análise pessoal vale lembrar que o simples fato de haver uma aula de inibição ao redor de um disco não significa obrigatoriamente que o microrganismo é sensível a droga a sensibilidade ou resistência é determinada pelo tamanho do audio
inibição que é específico para cada antimicrobiano por outro lado a ausência do halo indica obrigatoriamente resistência apesar de sua relativa simplicidade de execução a metodologia de disco-difusão exige que as instruções serão seguidas rigorosamente de forma que os resultados obtidos correspondam à realidade e possam ser comparado com as tabelas internacionais essa foi nossa aula de tsa usando métodos qualitativos espero que tenham gostado até a próxima vídeo aula de bacteriologia e e aí e aí